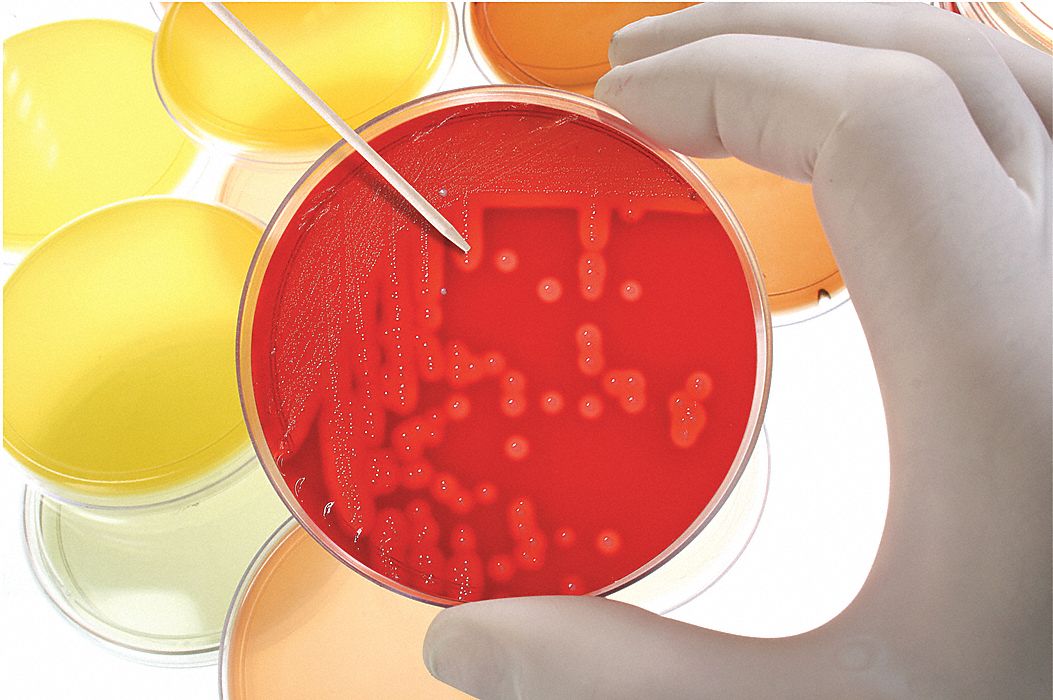
Pacificink

Refine your Results |

LOVIBOND Chlorine Rfrnce Stndrd Kit 12Mnths Glass $196.30 / EA 24AR03 | 
LOVIBOND Water Quality Test Kit TestKit 0 to 1 sg $183.19 / EA 24AR06 | 
HEATHROW SCIENTIFIC Pipette Holder ABS/TPE Lime $178.12 / EA 24EN21 |

HEATHROW SCIENTIFIC Cooler Polycarbonate 0.5-2mL $252.49 / EA 24EN23 | 
HEATHROW SCIENTIFIC Cooler Polycarbonate 0.5-2mL $439.87 / EA 24EN24 | 
HEATHROW SCIENTIFIC Cooler Polycarbonate 0.5-2mL $488.02 / EA 24EN25 |

HEATHROW SCIENTIFIC Cooler Polycarbonate 0.5-2mL $255.18 / EA 24EN26 | 
HEATHROW SCIENTIFIC Cooler Polycarbonate 0.5-2mL $440.47 / EA 24EN27 | 
HEATHROW SCIENTIFIC Cooler Polycarbonate 0.5-2mL $484.37 / EA 24EN28 |

HEATHROW SCIENTIFIC Cooler Polycarbonate 0.2mL $488.75 / EA 24EN29 |
HEATHROW SCIENTIFIC Test Tube Rack Polypropylene Blue $141.96 / EA 24EN48 | 
HEATHROW SCIENTIFIC Test Tube Rack Polypropylene Blue $141.86 / EA 24EN51 |
Last
Next